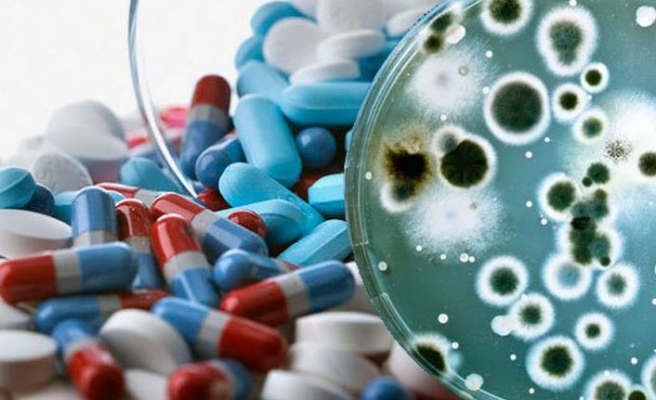

COVID-19 İÇİN GEREKSİZ ANTİBİYOTİK TÜKETİMİNE DİKKAT
Antibiyotikler yüzünden ülkedeki bütün mikroplara karşı güçlü bir direnç olduğunu ifade eden Ergönül, ''Bu durum antibiyotikler rahat rahat yazıldığı için oluyor.
Herkes corona virüse odaklanınca da bilinçsiz antibiyotik kullanımı göz ardı ediliyor'' dedi.
Antibiyotikler virüslerin neden olduğu enfeksiyonları önlemek veya tedavi etmek amacıyla kullanılmaz'' şeklinde cevap verildiği görülüyor.
"İŞE YARAMADIĞI ISPATLANDI" -
Türkiye'de corona virüs hastalarında yaygın bir antibiyotik kullanımı olduğuna dikkat çeken Prof. Dr. Önder Ergönül, 'İlk etapta, antibiyotiklerin de tıpkı hidroksiklorokin gibi yararlı olabileceği öne sürüldü.
Ergönül, Covid-19'un bir virüs olduğunu ve virüse karşı antibiyotiklerin etkisi olmadığını söyledi.
Oysa bu konuya dair bir kanıt olmadığı gibi bu tedavi biçimi önerilmiyor bile' açıklamasını yaptı.
HASTALAR İSTEDİĞİ İÇİN ANTİBİYOTİK YAZIYORLAR -
Türkiye'de antibiyotik kullanımına ilişkin çok yanlış bir algı olduğunu vurgulayan Ergönül, bazı hekimler elleri alışkın olduğu için bazı hekimler de hasta istediği için yazıyorlar.
'ÖZELLİKLE PANDEMİ DÖNEMİNDE DİKKAT ETMELİYİZ' -
Öte yandan bazı hastalarda antibiyotik tedavisinin gerekli olduğunu söyleyen Ergönül, sözlerine şunları ekledi:
'Corona virüs teşhisi konulan hastaların durumu bazen ağırlaşıyor ve hastaneye yatabiliyor. Bu hastalarda bazı durumlarda gerçekten de antibiyotik gerekebiliyor.
Ancak bu oldukça düşük bir ihtimal. Kesinlikle kullanılmaması gerekiyor diye bir iddiamız yok. Ancak özellikle pandemi döneminde antibiyotikleri daha akılcı kullanmaya ihtiyacımız var''
Dünya Sağlık Örgütü'nden (DSÖ) defalarca uyarı alan Türkiye'de bu durum tepkilere neden oldu.
Türk Mikrobiyoloji Derneği kongresinde gündeme gelen, 3 bin 406 hastayla yaptıkları araştırmada; ayaktan veya yatarak takip edilen Covid-19 hastalarının yüzde 72’sinin tedavisinde antibiyotik kullanıldığına yer verildi.
2015'ten bu yana, Dünya Sağlık Örgütü, (DSÖ) gereksiz antibiyotik kullanımı sorununa dikkati çekmek amacıyla 13-19 Kasım haftasını Dünya Antibiyotik Farkındalık Haftası olarak belirledi.
DSÖ, corona virüs pandemisinde gereksiz antibiyotik kullanımının bireye ve topluma yakın ve uzak gelecekte ciddi sağlık sorunları ve ekonomik kayıplar yaratabileceğine dikkat çekiyor.
Küresel bir tehdit haline gelen antibiyotik kullanımı için Türkiye'nin bu konuda 5 kez uyarıldığını ifade eden Ergönül, ''Aşırı antibiyotik kullanımı bakterilerde direnç geliştiriyor. Danimarka, İsveç gibi ülkelerde direnç oranları az çünkü antibiyotik tüketimi sıfıra yakın'' dedi.
''KANIT OLMADIĞI GİBİ ÖNERİLMİYOR'' -
Bazı hekimlerin bu açıklamaya 'biz bilmiyor muyuz' diyerek tepki gösterdiğini ifade eden Ergönül, ''Türkiye'de bazı hekimler, 'corona virüs tedavisinde yararlı olabilir' düşüncesiyle antibiyotik yazıyor.
Ya da şu an enfeksiyon yok ama olabilir diyerek yazabiliyorlar'' diyerek antibiyotik kullanımına ilişkin hastayı bilgilendirmenin gerekliliğini vurguladı.
Ergönül, ''Bakteriyel direncin artması bir süre sonra antibiyotikleri etkisiz hale geliyor. Bu gereksiz kullanım başımıza ileride büyük dertler açabilir.
İnsan sağlığını tehdit eden bilinçsiz kullanım, kendisini corona virüs tedavisinde de gösterdi.
Clinical Infectious Diseases dergisinde 21 Ağustos 2020’de yayımlanan bir makaleye göre, araştırmaya dahil edilen Covid-19 hastalarının yaklaşık yüzde 57’si erken ampirik antibiyotikler alırken yalnızca yüzde 3.5’i onaylanmış toplum kaynaklı bakteriyel infeksiyona sahipti. Bazı hastanelerde, Covid-19 hastalarında erken ampirik antibiyotik kullanımı yüzde 84’e kadar çıkıyor.
Antibiyotik direnci Türkiye'nin baş ettiği bir başka sağlık sorunu'' uyarısında bulundu.
Bunun nedeni leblebi, çekirdek gibi antibiyotik kullanılmasından oluyor'' diyerek hastaların antibiyotik yazıldığı durumlarda hekimlerine neden sorusunu sormasını önerdi.
''LEBLEBİ ÇEKİRDEK GİBİ KULLANMAYIN'' -
Konuya ilişkin örnek veren Ergönül, ''Mesela bir idrar yolu enfeksiyonu düşünün. Tedavisi çok basittir. Ancak verilen antibiyotikler işe yaramazsa ciddi sorunlar yaratabilir.
Ama daha sonra antibiyotiklerin corona virüs tedavisinde işe yaramadığı defalarca kez ispatlandı'' dedi.
SAĞLIK BAKANLIĞI ÖNERMİYOR -
Sağlık Bakanlığı Covid-19 Bilgilendirme Sayfası'nda yer alan, ''Covid-19 antibiyotiklerle tedavi edilebilir mi?'' sorusuna, ''Hastalığın etkeni bir virüs türüdür (SARS-CoV-2).
Özellikle pandemi döneminde gereksiz ve bilinçsiz antibiyotik kullanımının corona virüsü daha ölümcü hale getirebileceğine belirten Enfeksiyon Hastalıkları ve Klinik Mikrobiyoloji Uzmanı Prof. Dr. Önder Ergönül, konuyla ilgili soruları yanıtladı.
Antibiyotikler; aşırı, gereksiz ve yanlış kullanım nedeniyle zamanla 'tedavi edici' özelliklerini yitiriyor. Dünya çapında bakterilerin antibiyotiklere karşı direnci gittikçe artıyor.